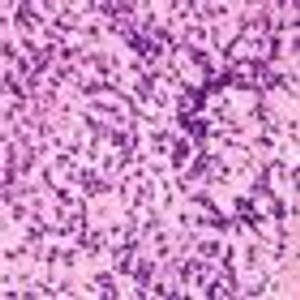
EPOCH-Rituximab Therapy Obviates Need for Radiotherapy in B-Cell Lymphoma

A dose-adjusted regimen of etoposide, doxorubicin, and cyclophosphamide with vincristine, prednisone, and rituximab (DA-EPOCH-R) obviated the need for radiotherapy in patients with primary mediastinal B-cell lymphoma in a single-group, phase II, prospective study.